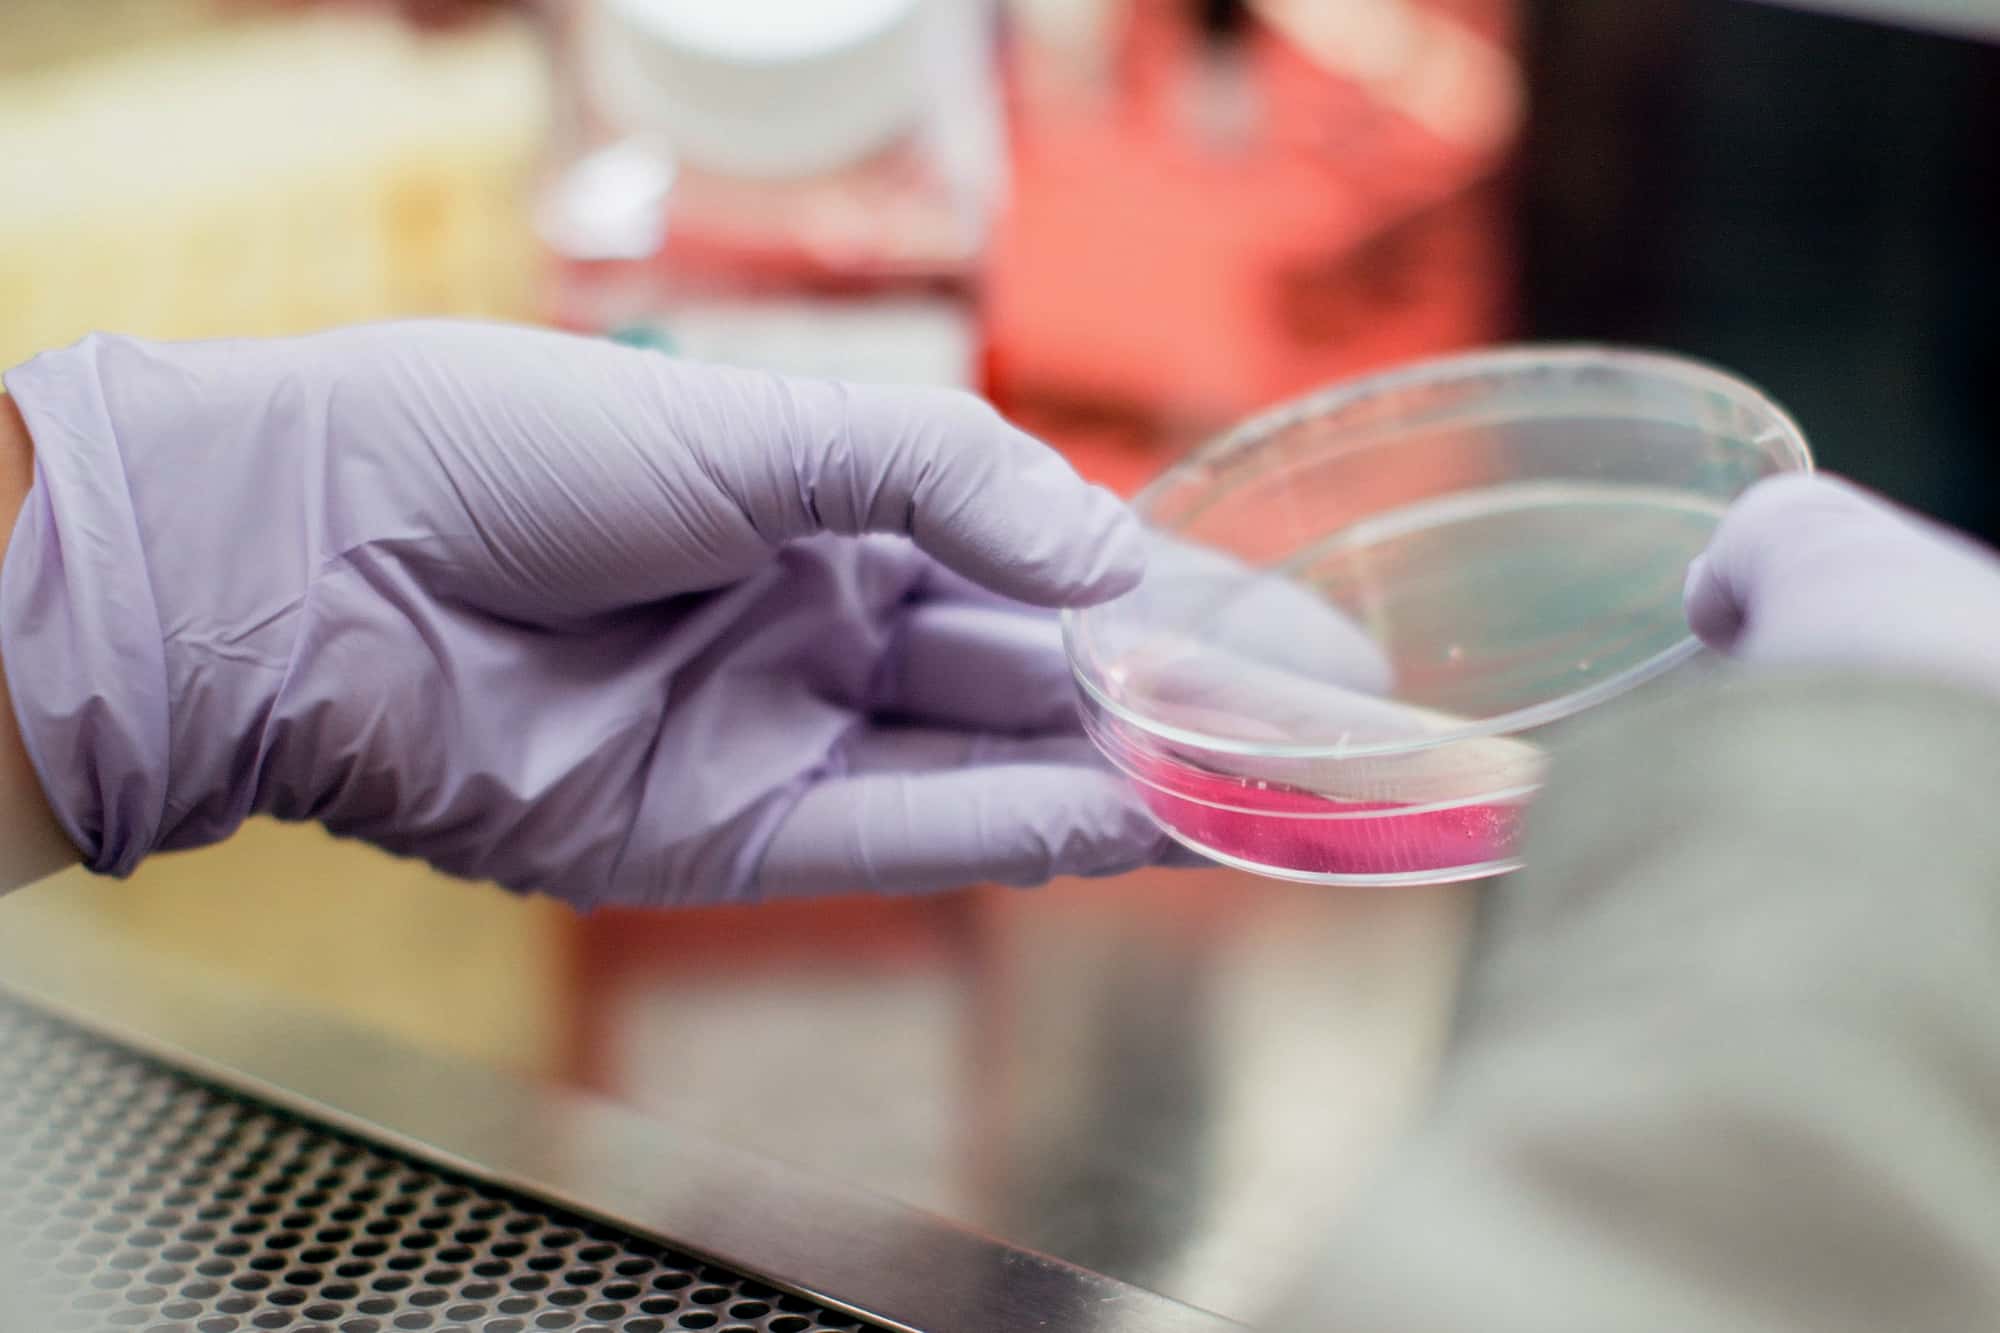
Two hands are holding a petri dish in the laboratory

Problem solver, UX whisperer, tool enthusiast, brand addict, tech nerd, wireframe scribbler, and always intrigued to learn something new.
Work
Fields of Expertise
-
As a UX conceptual professional, I specialize in creating user-centered experiences by leveraging my expertise in a variety of fields. These include conversational design, SaaS, product management, evolutionary design, and iterative product development. Additionally, I am well-versed in e-commerce, problem analysis, and user research, form design and crafting effective UX copy.
My skills extend to product strategy and ideation, multilingual applications and apps for Android and iOS. I am also experienced in creating responsive and mobile websites, as well as incorporating microinteractions and typography into my conceptual designs. By combining this knowledge, I help businesses create engaging, user-friendly products that deliver value to their customers. More About Erik Scholz
Services
- UX Concepts
- Growth Optimization
- Evolutionary Strategy
- Product Design
Technologies
- Figma
- Notion
- Miro
- VWO
Brands
He is super fast, precise, creative, understanding and a great sparring partner.
It's always a pleasure to work with Erik. His work is fantastic and his feedback is priceless.
Erik’s visionary UX approach took us to the next level in many occasions.
As an awesome unicorn, Erik consistently impresses with innovative ideas and problem-solving skills.